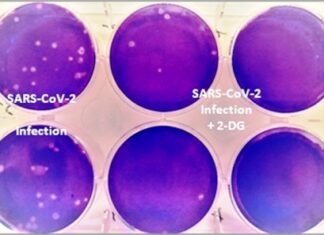
डॉ. रेड्डीज लेबोरेटरिज ने DRDO की 2-डीजी दवा को सैशे में किया लांच डॉ. रेड्डीज लेबोरेटरिज ने DRDO की 2-डीजी दवा को सैशे में किया लांच

संभाग स्तरीय निरीक्षण दल ने किया उर्वरक विक्रय केन्द्रों का आकस्मिक निरीक्षण
बलौदाबाजार- किसानों को सहज खाद उपलब्धता एवं खादों की कालाबाजारी ना हो इस उद्देश्य से आज राज्य शासन के निर्देश पर जिलें में संभाग...
जिले के सभी स्थायी एवं अस्थाई दुकानें रविवार सहित रात्रि 8.00 बजे तक खुलेगे
महासमुंद-पूरे छत्तीसगढ़ सहित महासमुंद ज़िले में भी अब कोरोना संक्रमण की गति धीमी होती जा रही है। कोरोना में लगातार कमी को देखते हुए...
सरदार मनदीप सिंह सुरक्षित भव: फाउंडेशन के बने डायरेक्टर
रायपुर-सुरक्षित भव: फाउंडेशन के सरदार मनदीप सिंह डायरेक्टर नियुक्त किए गए पदभार ग्रहण करने पर संस्था के पदाधिकारियों और शुभचिंतको ने शुभकामनाएं और बधाई...
खल्लारी के कांग्रेसजनों ने महंगाई को लेकर केन्द्र सरकार की खिचाई
खल्लारी- प्रदेश प्रभारी पी.एल.पुनिया, मुख्यमंत्री भूपेश बघेल, प्रदेश अध्यक्ष मोहन मरकाम, महासमुंद जिला कांग्रेस के प्रभारी कन्हैया अग्रवाल एवं जिला व ब्लाॅक कांग्रेस कमेटी...
खाद के स्टॉक में मिली गड़बड़ी, समिति प्रबंधकों को नोटिस जारी
बलौदाबाजार-कलेक्टर सुनील कुमार जैन के निर्देश पर किसानों को पर्याप्त मात्रा में उर्वरक उपलब्ध हो इसके लिए लगातार कृषि विभाग द्वारा जिलें के विभिन्न...
भाजपा नेताओं ने अठारहगुड़ी के ग्रामीणों से चर्चा कर सरकार के कार्यों का हिसाब...
पिथौरा -भूपेश सरकार के ढाई साल पूरे होने पर आज भाजपा नेताओं ने ग्रामीणों से चर्चा कर सरकार के कार्यों का हिसाब जाना। प्रदेश...
पेट्रोल-डीजल की बढ़ते कीमतों के विरोध पेट्रोल पंप में सांकेतिक धरना-प्रदर्शन
एमके शुक्ला-रायपुर:- प्रदेश कांग्रेस कमेटी एवं जिला कांग्रेस कमेटी रायपुर ग्रामीण व धरसिवा ब्लाक कांग्रेस कमेटी के निर्देशन अनुसार ग्राम पंचायत तेंदुआ के पेट्रोल...
डॉ. रेड्डीज लेबोरेटरिज ने DRDO की 2-डीजी दवा को सैशे में किया लांच
दिल्ली-सीएसआईआर की अंगीभूत प्रयोगशाला इंडियन इंस्टीट्यूट ऑफ केमिकल टेक्नोलॉजी (IICT) और हैदराबाद की एकीकृत दवा कंपनी ली फार्मा ने 2-डीऑक्सी-डी-ग्लूकोज के संश्लेषण के लिए...
परसदा से लोहझर तक बनेगा पक्का सड़क संसदीय सचिव ने किया भूमिपूजन
महासमुन्द- ग्राम परसदा से लोहझर तक पांच किमी तक पक्का सड़क का निर्माण किया जाएगा। आज सोमवार को संसदीय सचिव विनोद सेवनलाल चंद्राकर ने...
मेटल डस्ट पैलेडीयम की चोरी का पहला मामला, अन्तर्राज्यीय गिरोह के 07 गिरफ्तार
महासमुंद-जिले में पहली बार मारुति इको वाहन के साइलेंसर से कीमती मेटल डस्ट पैलेडीयम की चोरी करने का मामला सामने आया है पुलिस द्वारा...